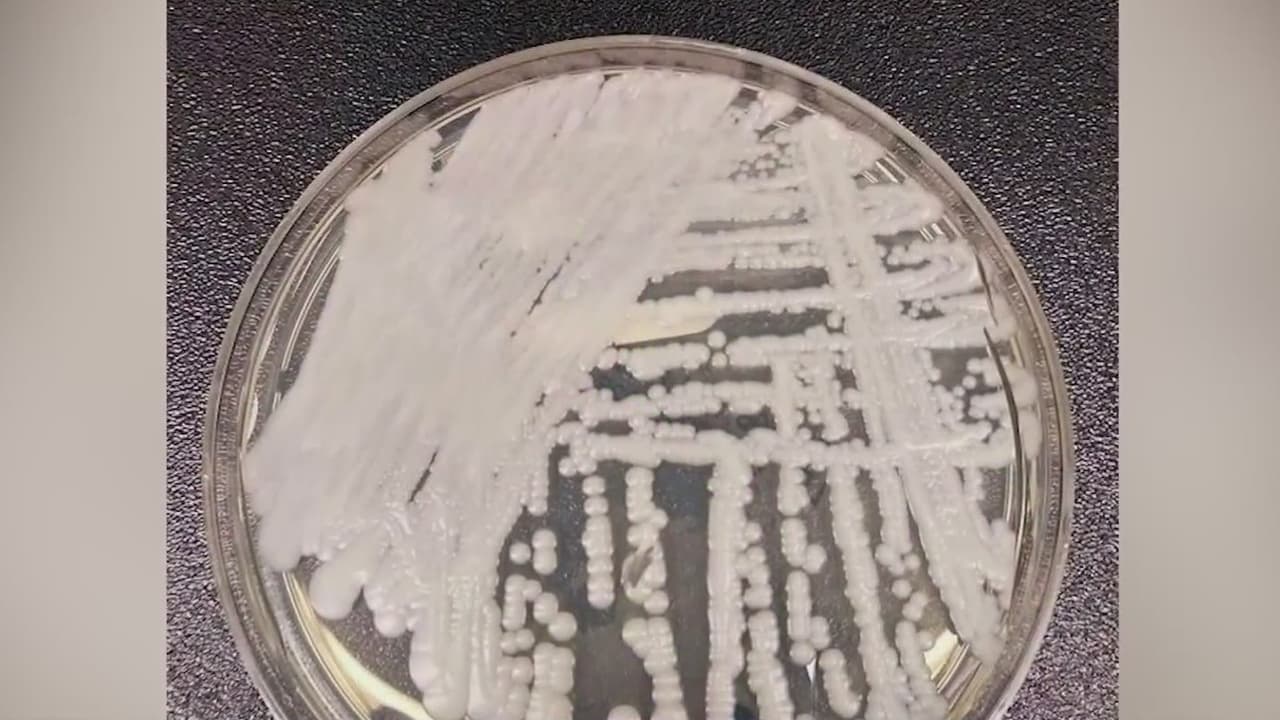

SAN FRANCISCO, California. – Un hongo resistente a los antibióticos y potencialmente mortífero se ha estado propagando a tasas “alarmantes” en los Estados Unidos, según un reporte de los Centros para el Control y Prevención de Enfermedades (CDC, por sus siglas en inglés).
Qué es Candida auris, el hongo resistente a antibióticos que se propaga de manera “alarmante” en EEUU
La principal preocupación de los CDC es que el hongo, llamado Candida auris, ha mostrado ser resistente al medicamento comúnmente recomendado para tratarlo.

La principal preocupación de las autoridades de salud es que el hongo, llamado Candida auris, ha mostrado ser resistente al medicamento comúnmente recomendado para tratarlo, triplicando el número de infecciones de 2019 a 2021.
Los CDC señalaron que el hongo Candida auris no representa una amenaza para las personas saludables. Sin embargo, los pacientes muy enfermos y personas que han sido sometidas a procedimientos médicos invasivos, así como aquellas con un sistema inmunológico débil, están en mayor riesgo de infección.
“Es cierto que no todos los antimicóticos funcionan y las mejores medidas de prevención son la higiene de todos los utensilios en estos lugares confinados a los adultos mayores y en los hospitales. Además, hay que tener especial cuidado con las personas que tienen inmunosupresión en el área hospitalaria”, explicó a Noticias Univision 14 la doctora Guillermina Mejía.
Las infecciones de Candida auris se triplican
Los datos del reporte de los CDC fueron publicados en el Anuario de Medicina Interna de los Estados Unidos y corresponden a un análisis realizado en casos de 2020 y 2021.
En ese último año, la agencia federal dijo que se triplicó el número de infecciones en las que el hongo se mostró resistente al medicamento ‘echinocandins’.
El documento calificó la tendencia como “una amenaza urgente” que se propaga de manera muy simple en los hospitales, además de que puede causar “infecciones severas con una alta tasa de mortalidad”.
La doctora Mejía menciona algunas de las formas en las que se puede reflejar en los pacientes:
“Es una infección que se da en personas con inmunosupresión, o sea que tienen comprometido el sistema inmune. ¿Cómo verlo, cómo saberlo? Se puede ver en las casas de adultos mayores donde la infección si puede propagarse y entrar por cualquiera de las vías digestivas o a piel”.
Y agrega: “¿Como darse cuenta? Pues hay colonización. Si es en piel se va a ver esta parte blancuzca. Pero insisto, mucha gente puede tenerlo y ni siquiera saber que tiene una infección por una levadura”, dice.
Los síntomas de Candida auris y qué tan riesgosa es la infección
Los CDC advierten que los síntomas del hongo en muchas ocasiones pueden pasar desapercibidos debido a que los pacientes contagiados en la mayoría de los casos ya están enfermos en los hospitales con otras condiciones o padecimientos serios.
Además, su visibilidad depende de la parte del cuerpo que sea afectada: por ejemplo, puede infectar el flujo sanguíneo, una herida o los oídos. Por lo tanto, es necesario realizar un estudio de laboratorio para determinar si una persona está infectada.
La agencia federal explica que cuando la infección es de carácter invasivo, se puede tornar muy seria e incluso letal. Un ejemplo es cuando afecta el flujo sanguíneo.
Los casos en los que un paciente infectado con Candida auris llega a fallecer se deben principalmente a que ya contaban con alguna otra enfermedad serie que aumentó su riesgo de fallecer.
¿Qué tan contagioso es el hongo Candida auris?
Las autoridades de salud federales señalan que aun cuando la infección fue tratada, el hongo pueden permanecer en la piel u otras partes del cuerpo del paciente, y si bien ya no les provocará síntomas o malestares, sí se puede propagar a otras personas.
Por lo tanto, el tratamiento especial para el paciente deberá continuar mientras el Candida auris siga latente en la piel u otras partes del cuerpo. En la mayoría de los casos, las precauciones deben tomarse a lo largo de toda la estadía del paciente en una institución médica.
Los CDC señalan que los pacientes infectados con el hongo sí pueden participar en actividades en grupo con personas no contagiadas, sin embargo, deberán tomar las siguientes precauciones:
- Lavarse las manos de manera regular
- Cubrir debidamente las heridas para evitar la propagación de fluidos
- Desinfectar utencilios que toquen y sean de uso común
De la misma forma, las personas que estén cuidando a uno de sus familiares infectados deberán lavar sus manos de forma regular después de tocar al paciente o alguno de sus utencilios médicos.